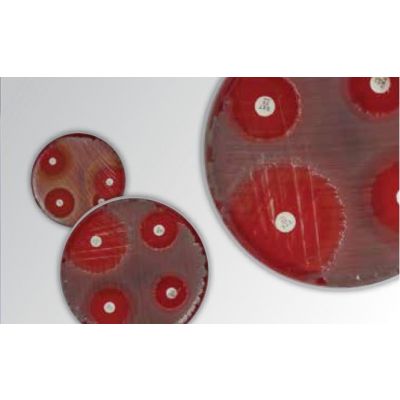
Discos de Suscetibilidade Antimicrobiana Thermo Scientific™ Oxoid™

Discos de Suscetibilidade Antimicrobiana Thermo Scientific™ Oxoid™
Fabricante:Thermo Fisher Scientific

Categorias:Microbiologia
Disponível em um variedade de compostos comuns e especializados e em diferentes concentrações, os discos Oxoid permitem que você alcance resultados de alta qualidade e atenda ao requisitos CLSI, EUCAST e BRCast.
Resumo
Disponível em um variedade de compostos comuns e especializados e em diferentes concentrações, os discos Oxoid permitem que você alcance resultados de alta qualidade e atenda ao requisitos CLSI, EUCAST e BRCast.
COMPARADOR
Adicione mais produtos
para comparar